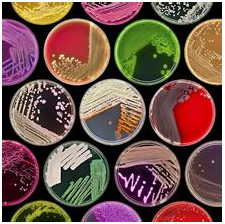

微生物培养的大神们看过来 这里的高聚蛋白胨真精彩
如果你不能正常浏览,请点击这里阅读

微生物培养的大神们看过来 这里的高聚蛋白胨真精彩
培养基原料
高聚蛋白胨, 可配制各种微生物培养基,用于细菌的培养、分离、增殖、鉴定,以及无菌试验培养基、厌氧菌培养基等细菌生化特性试验用培养基配置。
产品特点
产品正规
日本四大药业之一,严格按照日本药局方的药品生产规范制造。
非一般原料
来自食品安全把控严格的地区新西兰。
无外源污染
收录于日本药典和生物标准的无菌实验培养基的氮源较佳选择
大小总相宜
提供500克和25公斤两种包装,适合不同规模应用。
客户案例

“高聚蛋白胨在细菌的培养、分离、无菌试验培养基、厌氧菌培养基等特性试验中,用于控制结核杆菌的污染,效果很好。”
第一生化药厂
高经理
高经理

“多年来,我们一直选择高蛋白胨配置培养基,进行商业葡萄酒酵母酿酒酵母的物种的筛选。”
啤酒厂生产部
郝经理
郝经理
行业应用

生物医药
用于Dubos & Middlebrook的结核菌培养基和其他微生物的大量培养基。

食品卫生
啤酒厂使用蛋白胨配置培养基,做商业葡萄酒酵母酿酒酵母的物种的筛选。
活动介绍
西宝生物现货供应高聚蛋白胨

线下订购85折
移动端订购享受75折
赶紧拨打参加活动,
400-021-8158
好活动有期限, 好机会要抓住!
400-021-8158
好活动有期限, 好机会要抓住!
西宝生物®是中国生命科学领域优选的系统供应商。客户包括学术界、工业界和研究和开发实验室以及制药、生物技术、分析化学、检测机构、环境监测、食品工业、化工石化企业。我司自营进出口提供超过100万种产品,可提供定制、海外代购出口推广服务。

![]() |
![]() |
![]() |
官网:www.cxbio.com | 微信服务号:iseebio | 微博:seebiobiotech |
![]() |
![]() |
![]() |
商城:mall.seebio.cn | 微信订阅号:seebiotech | 泉养堂:www.canmedo.com |
此文关键字:高聚蛋白胨
相关资讯
- 西宝生物 洁净室检验报告
- Science:重磅!新发现挑战染色体组装经典模型
- 研究人员发现更安全的肝素生产方法
- Nature:针灸不再是“玄学”!中美科学家首次证明针灸的神经解剖学原理
- 蛋白质修饰研究现状与未来
- 支持CPG固相修饰 CPG solid supports - Lumiprobe DNA专用染料(2)
- 稀土金属粉、锭详细列表
- 感染和发炎研究用Elisa试剂盒
- 二恶英分析样品前处理专用耗材
- 致死率提高82%!这些新冠变异毒株会成为下一个Delta吗?
新进产品
同类文章排行
- 核苷酸类产品在生化诊断中的应用
- L-012化学发光探针
- 细胞培养级硫酸葡聚糖钠盐(DSS)
- 胆碱酯酶检测原料一览
- 猴痘病毒检测原料(涵盖诊断酶、抗原、抗体),西宝生物助力猴痘检测
- 西宝生物CHO细胞、HEK293细胞、 Vero细胞培养基产品
- 人和动物免疫球蛋白IgG新上市
- 如何选择合适的表面活性剂?
- 尿液分析试纸检测原理及产品推荐
- 总胆红素/直接胆红素检测一站式解决方案
资讯文章
您的浏览历史
